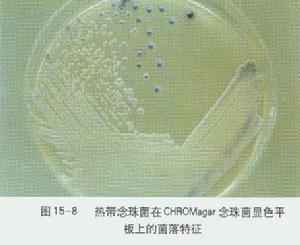
熱閉證

熱閉證
熱閉證熱閉證是邪熱亢盛,內外俱實的病證。見 《此事難知·熱有虛實外何以別》 。因熱邪入侵,里熱熾盛,或痰瘀,宿食阻滯所致。證見壯熱煩躁,面紅目赤,渴喜冷飲,胸痛痰黃、腹痛拒按,大便秘結,小便短赤,舌紅苔黃,脈洪數、滑實等。治宜清熱瀉火,選用白虎湯、調胃承氣湯、小陷胸湯、防風通聖散等方。參見實證、熱證條。
辯證要點
①本證以血液不足,臟腑組織失於濡養為主要病機。
②以面色萎黃,或面、舌、唇、爪甲色淡白、脈虛而細為辨證依據。
③血虛證以心、肝兩髒為多見,故有心悸、失眠多夢,或頭暈目眩、手足拘攣麻木、月經量少色淡等心、肝病症的定位症狀。
病因病機
 熱閉證
熱閉證足少陽膽經與足厥陰肝經互為表里,熱毒熾盛,正氣不支,邪陷厥陰,擾動肝風,蒙蔽心包,可出現高熱不退、抽風、昏迷等症。
機制分析
血行不暢,運行阻滯是本證主要病機。凡離開經脈的血液;未能及時排出或消散,而停留於某一處;或血液運行受阻,壅積於經脈或器官之內,呈凝滯狀態,失去生理功能者,均屬瘀血。由瘀血內阻而產生的證候,是為熱閉證。
